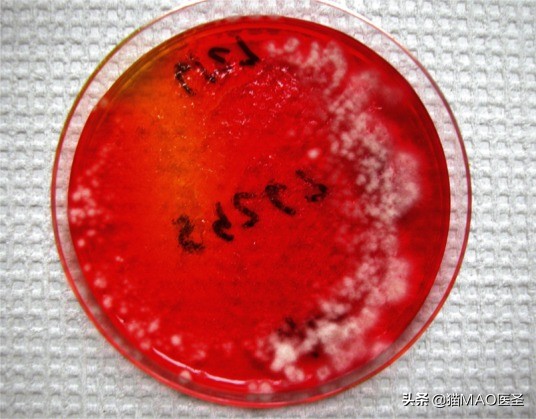
猫咪皮肤病症状及图片,猫咪皮肤病真菌
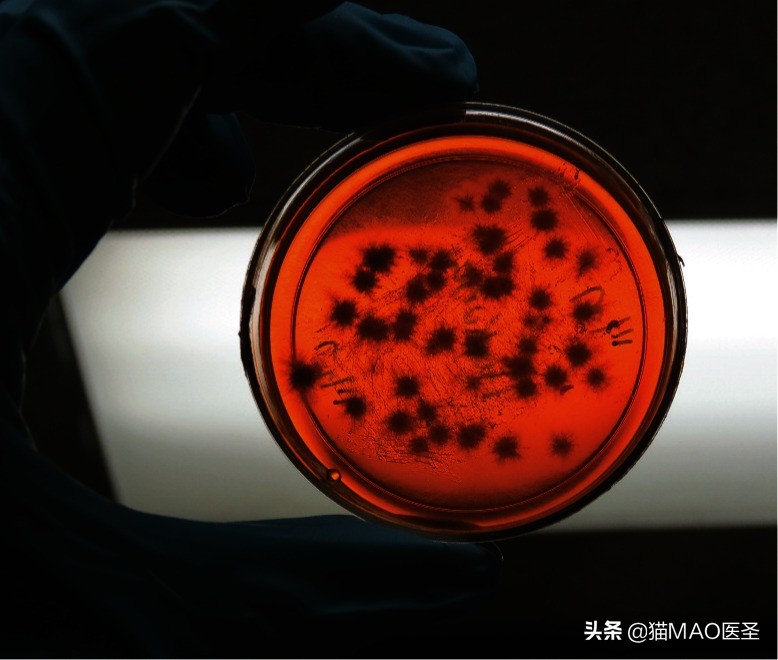
猫咪皮肤病症状及图片,猫咪皮肤病真菌

皮肤真菌病具有高度传染性,但不危及生命,可治疗和治愈,容易通过直接接触感染,具有人畜共患的重要性。
从皮肤病学的角度来看,跳蚤、虱子、寄生虫、细菌等的感染也是如此。皮肤真菌病不仅传染性强,而且传染性强,与其他传染病(如上呼吸道疾病)有许多共同之处。
那么,是什么让这种疾病与其他疾病如此不同呢?首先,这是一种引起公众健康关注的传染性皮肤病。其次,常规的护理或初级保健程序(如接种疫苗、控制跳蚤的应用)并不能保护其他动物或动物种群免受这种疾病。最后,这种疾病影响到最受欢迎的猫种群(即小猫),因此,在收容所等场所做出及时和准确的诊断和适合情况的治疗决定非常重要。
猫皮肤真菌病是一种浅表的真菌性皮肤病。 最常见的分离病原体是犬小孢子菌。虽然在多猫的情况下,除犬小孢子菌以外的病原体很少与皮肤真菌病的暴发相关,但也可能发生桃色小孢子菌、石膏样小芽胞菌和毛癣菌的感染。
真菌皮肤病的流行病学
猫感染犬小孢子菌的流行程度是高度可变的,取决于地理区域、抽样的人口、文化状况是否与疾病相关以及数据收集和报告的标准。
在过去20年中,在欧洲和美国进行的各种真菌培养调查中,发现猫的患病率从4-100%不等。然而,这些数字可能非常具有误导性,并可能过高估计了由猫的污染物传播(即机械性传播孢子)造成的实际疾病患病率。例如,在一项动物收容所的回顾性研究中,对比了筛查培养物和培养后检查,来自5644只猫的24个月的数据显示584只猫培养阳性(10.3%),在381/5644只猫(6.75%)入院时发现了皮肤损伤。然而,只有94/5644只猫同时感染和培养阳性(1.6%);其余490只培养阳性的猫为污染物携带者(不含病菌,重复培养阴性)。
污染物的携带是猫皮肤真菌病的一个重要问题,因为它会导致假阳性的真菌培养。这些错误的信息反过来会导致误诊和/或不必要的长期治疗和封闭治疗,甚至是安乐死。当怀疑有皮肤真菌病时,特别是当有许多猫被感染时,重要的是要清楚地了解污染物携带者和真正被感染的猫之间的区别。
传播和病理
皮肤真菌病的传播取决于许多因素,包括但不限于感染物质的数量、接触频率、猫的整体健康和生理应激。
通过猫对猫的直接接触接触感染性孢子是最常见和最重要的传播途径,也是最高的危险因素。猫还可能通过接触受污染的毯子、被褥、玩具、刷子、实验室工作服、皮手套甚至外部寄生虫而接触到感染性孢子。目前尚不清楚在没有同时进行的创伤性接种的情况下,非猫-猫传播实际上导致临床疾病的频率,但很清楚的是,机械传播可能导致假阳性培养结果,使管理和治疗复杂化。
孢子在空气中传播的问题不可避免地出现在私人住宅和庇护所中。一项调查抽样调查了在家中自由走动的受感染的猫,并记录了放置在家中不同高度的接触板上的真菌孢子。关于孢子通过加热和冷却管道传播的环境污染的可能性的问题是很常见的,特别是当许多猫都参与其中的时候。在一项现场研究中,在一个专门的处理设施中监测了孢子的空气传播。在随机取样的日子里,放置在强制空气加热孔上的接触板从未被发现有培养阳性,即使有时有超过20只猫出现在该设施中。然而,在这段时间内,熔炉过滤器总是培养阳性,这表明受感染的毛发和孢子被吸入通风口,困在熔炉过滤器中,没有被吹到整个设施。合理的限制在一个容易清洁的房间或区域,定期清洁和使用高质量的炉过滤器,使这是一个低风险的传播点。
大多数教科书介绍说2-4周的潜伏期,但有证据表明活动性感染发展得更快。 感染性孢子与皮肤接触,并发微创伤是疾病发生的必要条件。毛癣菌感染的实验模型显示,在数小时内,附着在表皮上的孢子数量随时间的增加而增加,随后孢子萌发并侵入角质层。有研究表明,种菌丝在接种7天后开始形成分生孢子。
2008年,Tabart等人报道了一种复杂的重建滤泡间猫表皮(RFE)的模型,其中角质层和皮肤通透性与体内情况相似。采用相同的模型,M犬关节分生孢子在接种后2小时内开始粘附于RFE,并在接种后6小时内数量增加。培养阳性的部位,5天内组织学记录了入侵。另一项使用猫的M犬感染实验模型的研究发现,猫的毛发在接种后7天内受到感染,并在接种部位出现病变。
皮肤真菌病因其临床表现的可变性而臭名昭著。
最常见的临床症状包括脱发、结痂和红斑的任何组合,有或没有瘙痒,而且,这些症状与广泛的非皮肤真菌皮肤病相似。
- 单纯感染这一组包括被证实感染的猫或小猫,这些猫或小猫在其他方面是健康的,没有受到生理压力。病变明显,但程度有限。只要猫咪保持健康,没有压力,并接受适当的预防护理,它们就会对治疗产生良好的反应。

- 复合感染包括有广泛的病变、炎性病变、长/纠结的毛发、其他疾病(最明显的是上呼吸道感染)、有既往治疗史和/或放弃抵抗性皮肤真菌病的猫。在许多情况下,对被毛的修剪揭示了病变的真实程度。由于病变程度、处理问题和/或其他健康因素,这些猫的治疗更加复杂。在某些情况下(如老年猫、上呼吸道感染猫),抗真菌治疗必须与已有疾病的治疗相协调。

- 无损伤/培养阳性,包括在其毛发上机械地携带孢子的猫和/或患有早期病变的猫,这些病变不容易被发现,但已经足够成熟,可以脱落关节孢子。真菌培养上的菌落形成单元(cfu),加上在室内的重新检查,有助于区分污染物携带者和早期损伤的猫。这些猫构成的一个主要风险是环境污染,这将混淆真菌培养的结果;或者,如果真的感染了,它们是易感猫的感染源。
还有一种特殊的情况,携带病原的猫在入院时没有发现损伤,伍德灯Wood’s lamp检查阴性。经复查,仍无损伤,培养阴性。通常这些猫的cfu/plate少于10。入院时感染的猫同样没有发现损伤,这些猫是伍德氏灯阴性。7-14天后,培养结果显示,伍德氏灯阳性和静止培养阳性。病变通常很小,通常位于耳朵、耳朵或耳朵附近、口鼻、手指之间、尾巴或腋窝。

进一步诊断检查
诊断上,结合病史、体格检查(结合白光检查)、Wood’s lamp检查、荧光毛发直接检查和真菌培养(cfu计数)用于评估猫的皮肤真菌病。
病史:多猫情况下(家、繁殖场所、猫舍或收容所)的疾病发生情况时,最初的目标是确定报告的“癣”是否存在。作为兽医,获取疾病史,并充分认识到获取时间线、疾病传播模式等的必要性。鼓励宠主/客户提供一个不间断的、不定向的说明他们为什么寻求帮助。这通常会提示关键信息。它有助于邀请宠主“把你记得的每件事都写下来,没有细节是太小的;包括你认为重要的东西。”
体格检查:对可疑的皮肤真菌病病例的检查包括触诊皮肤上可能找不到的病变,在室内灯光下检查以确定需要更仔细检查的区域,进行检查皮肤。
病变最常在以下部位发现:口鼻、唇、眼周、耳内及耳缘周围、手指、肢体内侧、腋窝及尾部。咬伤和抓伤在多猫的情况下很常见。注意任何部位的炎症,即使原因很明显(如耳螨,跳蚤),因为这可能是一个诱发原因,猫可能有一个以上的病变。虽然皮肤真菌病在表现上是可变的,但它是一种毛囊疾病和脱发,结垢/结痂和红斑在未经治疗的猫中很常见。
伍德灯检查:体格检查之后是伍德灯检查,它通常识别出在室内灯光检查中没有发现的病变(以发荧光的毛发显示)。伍德的灯发出长波紫外线辐射,并装有滤光片,滤光片对除320至400nm波段(峰值365纳米)以外的所有可见光都不透明。这通常被称为“黑光”,虽然理论上这可以描述广泛的灯,所以重要的是使用一个与适当的波长。
兽医医学中最常用的两种模型是一个小型手持式灯和一个稍微大一点的带有中心区域的装置,该装置允许放大部位。放大是一种重要的辅助手段,特别是在早期病变时。在最近的一项实验室研究中,从受感染的猫身上收集了200个牙刷样本,检查了它们的鬃毛中是否有荧光毛。发现伍德灯阴性牙刷中有超过50%是阳性的。与使用放大镜或放大镜来检查猫相比,这个装置不那么轻便。

直接检查毛发:直接检查只适用于伍德氏灯阳性毛,并且可以确认感染,并允许在确定的真菌培养之前做出治疗决定。这将降低该病向易感人群和动物传播的风险,并最大限度地减少对环境的污染,而这将使监测工作复杂化。


简化诊断测试的建议如下:
- 检测伍德氏灯养的毛发
- 头发需要用镊子按生长方向拔下来,然后直接放入一小滴矿物油中。矿物油的优点是容易接近,不会损坏显微镜镜头。
- 一滴新的亚甲蓝可以加到矿物油中。易碎和受损的头发会吸收污渍,使它们更容易显现。
- 直接检查的一个潜在的令人沮丧的问题是很难在显微镜下找到可疑的毛发。这个问题很容易解决,只要把伍德的灯放在显微镜载玻片上,定位发荧光的头发,然后重新定位载玻片,使其进入视野。找到头发后,就可以使用正常的照明。
真菌培养:
即使直接检查发现头发受到真菌侵袭,也需要真菌培养来确认感染;出于医学/法律上的原因,仍然进行真菌培养。它仍然是诊断的“黄金标准”技术。
通过对不同市售真菌培养基的比较,发现接种的方便性和最大的真菌培养基体积是最佳的。一般来说,DTM是推荐的,因为存在或不存在红色指示剂有助于早期鉴别高度可疑的培养物,以及在显微镜检查之前对板进行分类和评估。
抽样的最佳方法:已经描述了几种不同的获取样本的方法(例如,使用牙刷、纱布或商用抹布)。最常见的方法是用牙刷收集样本,然后将刷毛轻轻刺入真菌培养板表面。首选牙刷,因为早期感染的头发很小,而且靠近皮肤表面;孢子也更有可能被困在刚毛中,因此被取样。在许多情况下,对猫进行牙刷取样比其他方法更容易,也更安全。此外,该技术最大限度地降低了在监测治疗期间假阴性真菌培养的风险。当比较各种方法时,她发现地毯和牙刷在这方面是相同的,但纱布和商用抹布通常会产生假阴性培养物(未发表的数据)。
如何将暴露和交叉污染的风险降至最低:无论采用何种筛查技术,都应该对猫咪病变进行取样,直到取样工具上有可见的毛发为止。如果存在病变,最后取样这些区域,以避免在被毛上散布孢子。为了最大限度地减少接触人员和/或交叉污染的风险,应立即建立培养物或对样品进行双袋包装。如果要对大量的猫进行采样,建议使用预先打印的标签,以便方便地记录猫的姓名、性别、毛发长度、病变状态和伍德灯检查结果。减少交叉污染的一个简单方法是将真菌培养板“倒过来”接种在消毒湿巾上,这样当感染性孢子从牙刷或地毯上掉下来时就能将它们困住。
如何避免残余局部治疗的混杂效应:重要的是要确保不获得假阴性结果,因为任何局部治疗的残余作用。这可以通过接种从中心开始并在离心方向上继续的圆形板来实现。如果存在残留的局部治疗,它将在最初的几次刺入时沉积到琼脂中,任何生长都将在周围刺入处生长。
如何测量培养物以进行监测和筛选:使用cfu来评估感染的严重程度在20世纪中期首次被描述,当时豚鼠皮肤真菌感染的实验模型正在被开发。这项技术后来被应用于治疗猫的皮肤真菌病的研究,随后被应用于收容所,作为筛查方案的一部分,并用于监测治疗。该系统已被广泛用于庇护所进行筛选和治疗决策,并已被用于研究庇护所中皮肤真菌病治疗的现场研究。

每天检查培养物,每周记录结果。每日检查确保红色变化,如果培养皿中有过多的污染物,应将其丢弃,并决定是否在猫身上重复培养。阴性的培养物应保持21天,以确保没有病原体的后期生长(如毛癣菌种或犬小孢子菌的处理后培养物)。感染了犬小孢子菌的猫在第14天99%的培养物呈阳性。一旦获得培养结果,就应尽快作出治疗决定。
对于真菌性皮肤病一定要准确诊断,不要拉下每一步,否者可能造成猫咪皮肤病复杂化,使病程延长,难以治疗,对猫咪的皮肤造成严重伤害!
